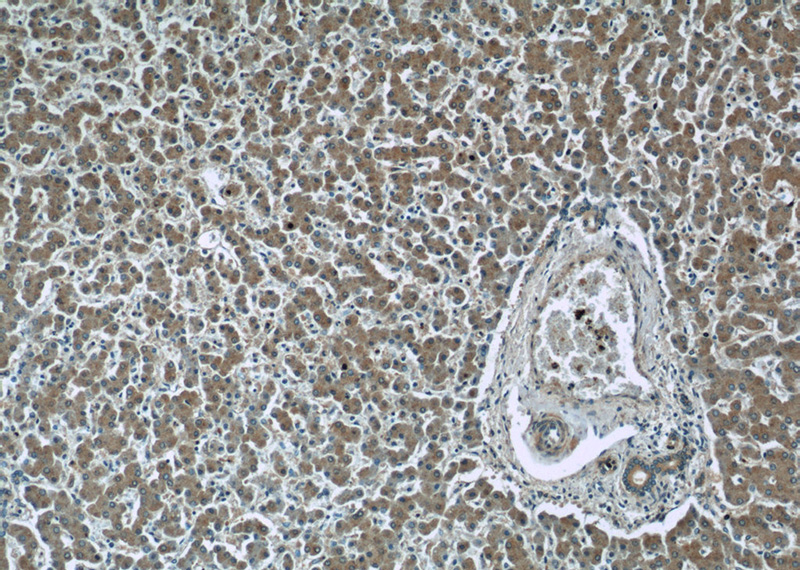
Immunohistochemistry of paraffin-embedded human liver slide using Catalog No:111197(GRB10 Antibody) at dilution of 1:50

-
Product Name
GRB10 antibody
- Documents
-
Description
GRB10 Rabbit Polyclonal antibody. Positive IHC detected in human liver tissue, human kidney tissue. Positive IF detected in HepG2 cells. Positive WB detected in mouse liver tissue, HeLa cells, HepG2 cells, mouse brain tissue, rat brain tissue. Observed molecular weight by Western-blot: 60-70 kDa
-
Tested applications
ELISA, WB, IF, IHC
-
Species reactivity
Human, Mouse, Rat; other species not tested.
-
Alternative names
Grb 10 antibody; GRB IR antibody; GRB10 antibody; GRB10 adapter protein antibody; GRBIR antibody; IRBP antibody; KIAA0207 antibody; MEG1 antibody; RSS antibody
-
Isotype
Rabbit IgG
-
Preparation
This antibody was obtained by immunization of GRB10 recombinant protein (Accession Number: XM_017012064). Purification method: Antigen affinity purified.
-
Clonality
Polyclonal
-
Formulation
PBS with 0.02% sodium azide and 50% glycerol pH 7.3.
-
Storage instructions
Store at -20℃. DO NOT ALIQUOT
-
Applications
Recommended Dilution:
WB: 1:500-1:5000
IHC: 1:20-1:200
IF: 1:20-1:200
-
Validations

mouse liver tissue were subjected to SDS PAGE followed by western blot with Catalog No:111197(GRB10 antibody) at dilution of 1:1000
Immunohistochemistry of paraffin-embedded human liver slide using Catalog No:111197(GRB10 Antibody) at dilution of 1:50

Immunofluorescent analysis of HepG2 cells, using GRB10 antibody Catalog No:111197 at 1:50 dilution and Rhodamine-labeled goat anti-rabbit IgG (red).
-
Background
Growth factor receptor-bound protein 10 (GRB10) is an adapter protein which modulates coupling of a number of cell surface receptor kinases with specific signaling pathways. GRB10 has three consensus domains including pleckstrin homology (PH) domain, SH2/SH3 domain and Ras-associating domain. By binding to kinases, GRB10 suppresses signals from activated receptors tyrosine kinases, including the insulin (INSR) and insulin-like growth factor (IGF1R) receptors. It may play a role in mediating insulin-stimulated ubiquitination of INSR, leading to proteasomal degradation.
-
References
- Xia HF, Cao JL, Jin XH, Ma X. MiR199a is implicated in embryo implantation by regulating Grb10 in rat. Reproduction (Cambridge, England). 147(1):91-9. 2014.
- Park Y, Jin HS, Lopez J. TSC1 regulates the balance between effector and regulatory T cells. The Journal of clinical investigation. 123(12):5165-78. 2013.
Related Products / Services
Please note: All products are "FOR RESEARCH USE ONLY AND ARE NOT INTENDED FOR DIAGNOSTIC OR THERAPEUTIC USE"
